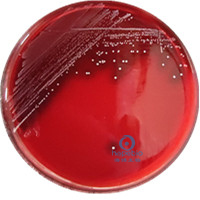
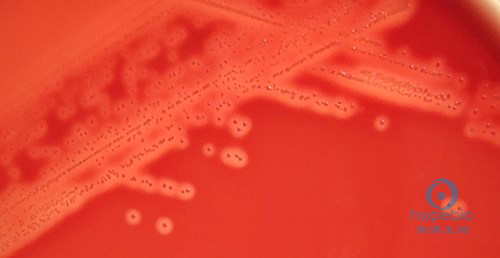
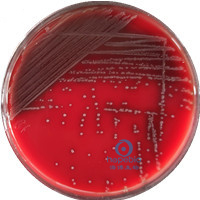
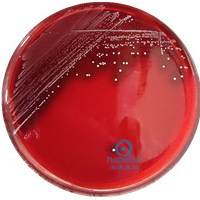

海博微信公众号
海博微信公众号
 海博天猫旗舰店
海博天猫旗舰店


 海博微信公众号
海博微信公众号
 海博天猫旗舰店
海博天猫旗舰店




溶血性链球菌,顾名思义为有溶血作用的链球菌,革兰氏阳性菌,需氧或兼性厌氧培养。链球菌根据其对红细胞的溶解作用程度不一,又可分为α(甲)、β(乙)、γ(丙)三型。其中β-溶血性链球菌,具有完全溶血作用,其在血平板上生长产生的溶血素可在菌落在周围形成一个2-4mm、界限分明、完全透明的无色溶血环。α-溶血性链球菌产生的溶血环又称草绿色溶血,菌落周围培养基出现1-2mm的草绿色环。γ-链球菌不产生溶血素,无溶血环。
溶血性链球菌广泛存在于水、空气等自然环境及健康人和动物的口腔、鼻腔、咽喉中,溶血性链球菌通常通过以下途径污染食品:①食品加工人员及其他直接接触人员有化脓性炎症时手口鼻接触或空气飞沫污染。②食品原材料带菌,如畜禽局部化脓。③熟制品因包装不善而使食品受到污染。被污染的食品会使人类通过直接接触或皮肤、黏膜伤口等多种方式感染,危害极大,其中β溶血性链球菌危害最大。
本文将按不同标准对β溶血性链球菌的检验进行介绍,以GB4789.11-2014《食品安全国家标准》为主。
一、GB4789.11-2014《食品安全国家标准》
(1)样品处理及增菌培养
按无菌操作称取检样25g(25mL),加入盛有225mL mTSB的均质容器(均质袋、均质杯、锥形瓶等)中,充分均质,36±1℃培养18-24h。
mTSB对β溶血性链球菌进行选择性增菌。其中多粘菌素B通过破坏细菌外膜的完整性来抑制或杀灭革兰氏阴性菌;萘啶酮酸则通过干扰DNA合成抑制大多革兰氏阴性菌的繁殖;胨类提供碳源、氮源和维生素等;葡萄糖提供可发酵糖类;氯化钠维持渗透压;磷酸氢二钾做为缓冲剂。此培养基不能抑制肠球菌和葡萄球菌等大多革兰氏阳性菌,故在后续检验中需将其排除。
(2)分离及纯化培养
将增菌液划线接种于哥伦比亚CNA血琼脂平板,36±1℃厌氧培养18-24h。
β溶血性链球菌在哥伦比亚CNA血琼脂平板上的典型菌落为边缘整齐圆形、灰白色、半透明、表面光滑、有乳光凸起的的细小菌落,产生β溶血,如图1、图2所示。
图1 β溶血性链球菌在血平板上的菌落特征
图2 β溶血环
此步骤是厌氧培养,是因为溶血性链球菌多为兼性厌氧,可在厌氧环境下生长,可减少样品中其它专性需氧菌的干扰。通过菌落特征可将大多有色素的球菌与β溶血性链球菌区分,如葡萄球菌通常为不透明菌落。β溶血环的存在与否可将不溶血或α溶血的球菌与β溶血性链球菌区分,如部分葡萄球菌、部分肠球菌等。
(3)革兰氏染色镜检及触酶试验
1、革兰氏镜检
β溶血性链球菌为革兰氏阳性、球状或卵圆形菌,链状排列且长短不一,一般为4-8个或几十个细胞排列成链,无芽孢、无鞭毛、多数无荚膜。
β溶血性链球菌衰老培养物染色结果为革兰氏阴性,故应取用新鲜培养物进行染色;其在固体培养基上多为短链或葡萄状,在液体中链状较为典型,生长如图3所示。

图3 β溶血性链球菌在BHI中24h培养物革兰氏染色后镜检结果
2、触酶试验
β溶血性链球菌触酶试验为阴性。挑取可疑菌落于洁净的载玻片上,滴加适量3%过氧化氢溶液,立即产生气泡者为阳性,如葡萄球菌、糖球菌;或者用玻璃棒或毛细管蘸取可疑菌落于3%过氧化氢溶液中,立即产生气泡者为阳性,如图4所示。
注:此试验必需保证纯菌,不能混杂有其它菌或物质,不能直接向平板上滴加3%过氧化氢溶液。

a:β溶血性链球菌;b:金黄色葡萄球菌
图4 触酶试验结果
3、某些易混淆菌辨别
①溶血孪生球菌
溶血孪生球菌具有革兰氏阳性细胞壁、可厌氧生长、在血平板上产生β溶血环、触酶阴性,易与β溶血性链球菌混淆。其在血平板上为透明略凸起、边缘不规则小菌落,可与β溶血性链球菌区分。其革兰氏染色为阳性但易褪色,故革兰氏染色常见红色紫色混合,常单个、成对或短链排列,成对排列时两细胞相邻面扁平。
②β溶血的肠球菌
肠球菌兼性厌氧、接触酶阴性、在血平板上菌落状态同溶血性链球菌相差不大(如图5所示),革兰氏染色液难以区分,且某些肠球菌能产生β溶血,此类肠球菌可通过补加链激酶试验或40%胆汁肉汤试验来区分。β溶血性链球菌链激酶试验为阳性,肠球菌为阴性;40%胆汁肉汤试验β溶血性链球菌为阴性(不生长澄清),肠球菌为阳性(生长浑浊),如图6所示。
|
|
|
粪肠球菌 |
β溶血性链球菌 |
图5 血平板划线结果

a:空白对照;b:粪肠球菌;c:β溶血性链球菌
图6 40%胆汁肉汤试验结果
(四)生化鉴定(选做)
1、杆菌肽药敏实验
将可疑菌落的纯培养物涂布于血琼脂平板上,用灭菌镊子取每片含有0.04单位的杆菌肽纸片,放于涂布后的琼脂表面,需同时接种已知阳性和阴性菌株作为对照,于36±1℃培养24h,如有抑菌带出现即为阳性,如图7所示。

图7 β溶血性链球菌杆菌肽药敏实验结果
注:此试验于GB/T 14926.16-2001 《实验动物 乙型溶血性链球菌检测方法》和GB 15979-2002《一次性使用卫生用品卫生标准》中为必做试验。
2、40%胆汁生长
配制40%胆汁肉汤,接种可疑菌10-100CFU,需同时接种已知阳性菌和阴性菌作为对照,于36±1℃培养18-24h,生长即为阳性,澄清不生长即为阴性。
注:此试验不是必做试验,当有些可疑菌落通过革兰氏染色、菌落形态等难以辨别时,可选择此试验用以进一步鉴定。
(五)链激酶试验(选做)
吸取草酸钾血浆0.2mL(0.01g草酸钾加5 mL血浆混匀,经离心沉淀,吸取上清液),加入0.8 mL无菌生理盐水,混匀后再加入可疑菌18-24hTSB肉汤培养物0.5 mL和0.25%氯化钙0.25 mL,混匀,置于36±1℃水浴中。待血浆凝固后(一般为10min,试管倒置不流动),继续水浴培养24h观察结果,若血浆完全溶解则为阳性,不溶解为阴性。β溶血性链球菌链激酶试验为阳性。
注:草酸钾血浆在使用前需观察是否变质,变质常表现为有凝块,加入生理盐水后不能呈完全溶解状态,该状态草酸钾血浆不能使用,会影响后续结果判断。加入可疑菌培养物和氯化钙后应培养至血浆凝固才能继续培养,若不能凝固则不能进行后续试验判断。此试验在GB 15979-2002《一次性使用卫生用品卫生标准》和GB/T 14923.16-2001《实验动物 微生物学检验方法》中为必做试验。
二、关于溶血性链球菌的其它标准简单介绍
1、GB 15979-2002《一次性使用卫生用品卫生标准》B6溶血性链球菌检验方法:此标准中选用葡萄糖肉汤为增菌培养基,血琼脂平板为分离纯化培养基。镜检为革兰氏阳性链状排列球菌、血平板上出现溶血圈、链激酶和杆菌肽试验阳性,可报告检出溶血性链球菌。
2、GB/T 18204.3-2013《公共场所卫生检验方法》第3部分:空气微生物β-溶血性链球菌:镜检、菌落特征符合描述,有β溶血环即可判定为β溶血性链球菌。注意此标准中血平板培养时间为24-48h。
3、GB/T 14923.16-2001《实验动物微生物学检验方法》乙型溶血性链球菌检测方法:菌落特征和镜检菌体特征符合描述、链激酶试验阳性、杆菌肽敏感试验阳性,可报告检出乙型溶血性链球菌。
4、SN/T 4624.5-2016《入境环保用微生物菌剂检测方法》第5部分:β型溶血性链球菌:此标准从增菌到分离纯化到形态学及生化鉴定与GB4789.11-2014《食品安全国家标准》无明显区别,具体可参照国标介绍。
5、DB15/T 2071-2021《内蒙古自治区地方标准》动物垫料中β-溶血性链球菌检测:此标准从增菌到分离纯化到形态学及生化鉴定与GB4789.11-2014《食品安全国家标准》无明显区别,具体可参照国标介绍。
6、SN/T 2754.9-2011《出口食品中致病菌环介导恒温扩增(LAMP)检测方法》第9部分:溶血性链球菌。
注:本文属海博生物原创,未经允许不得转载。
上一篇:霍乱弧菌检验方法及结果判断
下一篇:食品中志贺氏菌的检验(下)
| 相关文章: | |
| 咽拭子标本中A群β溶血性链球菌的快速直接测定 | |



